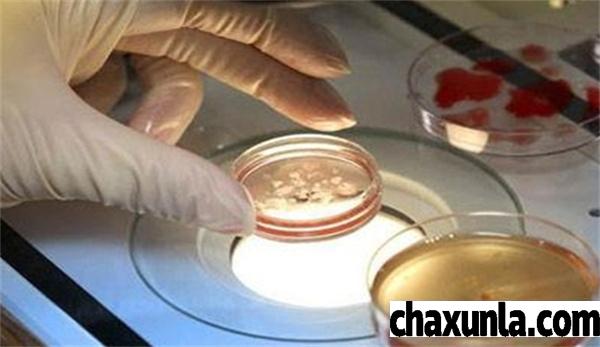

最佳回答
本文由作者推荐
简要回答
试管婴儿其实作为辅助技术当中的一种,通常将男性的精子和女性的卵子取出体外,在体外培养敏当中形成受精卵发育成胚胎胚胎再次移植到女性身体当中,一般宝宝的生长发育主要在女性的子宫当中。
详细内容
- 01
不过有部分小伙伴觉得试管婴儿其实就是在试管当中长大的孩子,殊不知并不是这样的,通常我们在生活中发现,子宫卵巢内取下卵细胞时,在实验室当中跟男性的精子结合产生胚胎。

- 02
对于大众来说,想要做试管婴儿手术也需要选择适合自身的方式,毕竟试管婴儿手术并不是适合所有的小伙伴。
- 03
人们在现实生活中选择做试管婴儿手术时,夫妻双方都需要去医院做相关的检查,通过检查之后确定自己是否符合做试管婴儿手术的条件,毕竟试管婴儿手术也会适应对应的人群。

- 04
一般夫妻双方决定做试管婴儿手术时,术前术后都是要做好充分的准备,这样才能够有效的提高试管婴儿手术的成功率。
广告位
点击排行
- 2 排行
- 3 排行
- 4 排行
- 5 排行
- 6 排行
- 7 排行
- 8 排行
- 9 排行
- 10 排行
热点追踪
广告位

